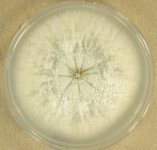

Search Details
| UAMH Number: | 10825 |
|---|---|
| Species Name: | Thyridium curvatum |
| Type: | |
| Synonyms: | Phialemoniopsis curvata / Phialemonium curvatum |
| Taxonomy: | FUNGI Ascomycota, Sordariomycetes, Cephalothecales, Cephalothecaceae |
| Strain History: | M. Libel -> Sutton, D.A. (UTHSC 06-4324) -> UAMH |
| Substrate: | pleural fluid (isolated 3 times), 2 yr old male poodle | Location: | USA Texas, College Station, Texas A&M University College of Veterinary Medicine (GEO: 30.613,-96.352) |
| Isolator: | M. Libel |
| Isolation Date: | 2006-10-27 |
| Date Received: | 2007-06-06 |
| Characters: | HUMAN/ ANIMAL PATHOGEN disseminated infection in canine - Sutton DA, Wickes BL, Thompson EH, Rinaldi MG, Roland RM, Libal MC, Russell K, Med Mycol 46:355-359, 2008 // MOLECULAR SYSTEMATICS characterization of Phialemonium and Lecythophora - Perdomo H, Sutton DA, García D, Fothergill AW, Gené J, Cano J, Summerbell RC, Rinaldi MG, Guarro J, J Clin Microbiol 49:1209-16, 2011 (Click for publications citing UAMH 10825) |
| Compounds: | |
| Cross Reference: | UTHSC 06-4324 // UTHSC R-3884 |
| Collections: | Living Strains; Dried Herbarium Material |
| Pathogenic Potential: | Human: yes | Animal: no | Plant: yes |
| Biosafety Risk Group: | RG2 (check the PHAC ePATHogen Risk Group Database for updates) |
| Regulatory Requirements: | Canadian requesters must provide PHAC Pathogen and Toxin License Number (see: https://www.canada.ca/en/public-health/services/laboratory-biosafety-biosecurity/licensing-program.html) and a CFIA Written Authorization for transfer (http://www.inspection.gc.ca/plants/plant-pests-invasive-species/directives/date/d-12-03/eng/1432656209220/1432751554580#app2) prior to shipment. International requesters must provide all legally required importation documentation prior to shipment. This strain is not available for shipment to Cuba, the Democratic People's Republic of Korea, Iran or Syria. Plant pathogenicity status may be verified by using the USDA Agricultural Research Service (ARS) Fungal Database |
| MycoBank ID: | 841921 |
| Sequences: | >UAMH10825_FR691981_LSU GGCCTCGGCCCGAGTTGTAATTTGTAGAGGATGCTTTTGGTGCGGTGCCTTCTGAGTTCCCTGGAACGGGACGCCTTAGAGGGTGAGAGCCCCGTAAAGTTGGACACCAAGCCTATGTAAAGCTCCTTCGACGAGTCGAGTAGTTTGGGAATGCTGCTCAAAATGGGAGGTAAATTTCTTCTAAAGCTAAATACCGGCCAGAGACCGATAGCGCACAAGTAGAGTGATCGAAAGATGAAAAGCACTTTGAAAAGAGGGTTAAAAAGTACGTGAAATTGTTGAAAGGGAAGCGCTTATGACCAGACTTGTGCCCTGCGGATCATCCAGCCTTCTGGCTGGTGCACTTCGCTTGGTTCAGGCCAGCATCGGTTTTCTGAGGGGGATAAAAGCTTCAGGGACGTGGCTCCTCCGGGAGCGTTATAACCTGTTGCA >UAMH10825_EU035985_LSU GCATATCAATAAGCGGAGGAAAAGAAACCAACAGGGATTGCCCTAGTAACGGCGAGTGAAGCGGCAACAGCTCAAATTTGAAATCTGGCCTCGGCCCGAGTTGTAATTTGTAGAGGATGCTTTTGGTGCGGTGCCTTCTGAGTTCCCTGGAACGGGACGCCTTAGAGGGTGAGAGCCCCGTAAAGTTGGACACCAAGCCTATGTAAAGCTCCTTCGACGAGTCGAGTAGTTTGGGAATGCTGCTCAAAATGGGAGGTAAATTTCTTCTAAAGCTAAATACCGGCCAGAGACCGATAGCGCACAAGTAGAGTGATCGAAAGATGAAAAGCACTTTGAAAAGAGGGTTAAAAAGTACGTGAAATTGTTGAAAGGGAAGCGCTTATGACCAGACTTGTGCCCTGCGGATCATCCAGCCTTCTGGCTGGTGCACTTCGCTTGGTTCAGGCCAGCATCGGTTTTCTGAGGGGGATAAAAGCTTCAGGGACGTGGCTCCTCCGGGAGCGTTATAACCTGTTGCAAAATACCCCTCGGGAGACCGAGGTTCGCGCATCTGCAAGGATGCTGGGCGTAATGGGTCATCAGCGACCCGTCTTGGAAACCCGGGACCCATATCATT >UAMH10825_EU035984_SSU-LSU AAAGTTATATTTCTCGCTGAGGTGAAATCTTGCGGGAGGGGATCATTAAAAGAGTTGCAAAACTCCCAAACCATATGTTTATCTACCTGTTTCGTTGCTTCGGCAGGCGGTTCTTCTGGAGCCTTCGCCCTTGGGTGCCTGCCGGAGTATCTAAAACTCTTGTTAATTACTGTTCTGTCTGAGTAAACTTTTAATAAGTTAAAACTTTCAACAACGGATCTCTTGGTTCTGGCATCGATGAAGAACGCAGCGAAATGCGATAAGTAATGTGAATTGCAGAATTCAGTGAATCATCGAATCTTTGAACGCACATTGCGCCCATTAGTATTCTAGTGGGCATGCCTGTTCGAGCGTCATTTCAACCCTCAAGCACTGCTTGGTGTTGGGGCGTCTGCAGCTCCGGCTGCAGGCCCTGAAAAACAGTGGCGGGCTCGCTATAACTCCGAGCGTAGTAATATATCCTCGCTTTGGAAGTGTAGCGGTTCCCGGCCGTTAAACCCCCCAATTTCTGAATGTTGACCTCGGATCAGGTAGGAATACCCGCTGAACTTAAGCATATCAATAAGCGGAGGA |
IMAGES: